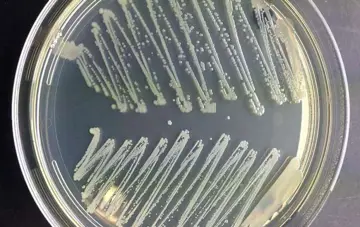

شماره ۹۴۶
دکتر انه که واندروالت ازمرکز پژوهشهای سلطنتی ملبورن دراسترالیا ومتخصص مغز و اعصاب در دورههای تکمیلی ملبورن میگوید که لرزش و تکانهای بیماران دچار ام اس(ms) به داروهای متداول جواب نمیدهد و بررسی و راههای جدیدی برای معالجه میطلبد.